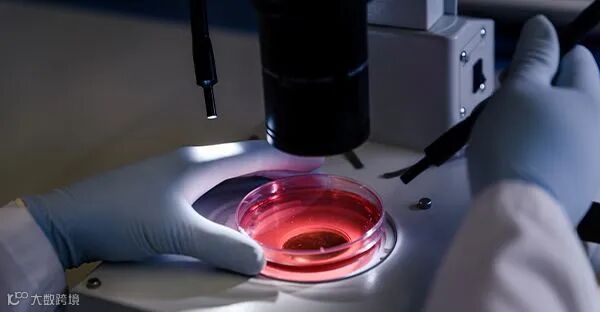

近日,深圳市发展和改革委员会关于发布2024年战略性新兴产业专项资金项目申报指南(第一批)的通知。围绕半导体与集成电路、生物医药、高端医疗器械、大健康、新能源、安全节能环保等战略性新兴产业重点领域,支持相关单位组织实施核心技术攻关、“医工融合”专项、市级工程研究中心组建和提升、市级重大产业公共服务平台组建、产业化中试、临床试验、产业化事后补助、新技术新产品应用示范推广、注册许可认证、国家项目配套等项目。
申报时间:2024年4月11日9:00至2024年5月10日18:00。
申报路径:项目单位登录广东政务服务网在线申报,申报网址为http://www.gdzwfw.gov.cn/portal/guide/11440300693966093K3442001031000,无需提交纸质版申报材料。国家项目配套扶持计划申报路径按照有关申报指南要求办理。
1.核心技术攻关扶持计划
扶持方向:
1.小分子化学创新药物、2.大分子生物创新药物、3.微生物创新药物
资助标准:
按经评审核定的项目总投资40%给予资助,最终资助金额按照项目实际完成情况、项目实际完成投资额、资助比例、专项资金使用管理情况等因素核定,最高不超过1000万元。
2.“医工融合”专项扶持计划

扶持方向:
重点支持医用机器人、人工智能体外诊断设备、高性能植介入器械等前沿领域企事业单位与本地临床医疗机构开展“医工融合”基础研究和技术攻关,推动重大装备、关键零部件等实现国产替代。1.医用机器人、2.人工智能体外诊断设备、3.高性能植介入器械
资助标准:
按经评审核定的项目总投资的40%给予资助,最终资助金额按照项目实际完成情况、项目实际完成投资额、资助比例、专项资金使用管理情况等因素核定,最高不超过1000万元。
3.市级工程研究中心组建与提升扶持计划

扶持方向:
1.市级工程研究中心组建、2.市级工程研究中心提升
资助标准:
市级工程研究中心组建按经评审核定的项目总投资的40%给予资助,最高不超过500万元;市级工程研究中心提升按经评审核定的项目总投资的40%给予资助,最高不超过500万元。
4.市级重大产业公共服务平台组建扶持计划

扶持方向:
半导体与集成电路领域:1.AI芯片设计验证公共服务平台、2.芯片设计和创新公共服务平台、3.自主化EDA工具公共服务平台、4.自主化车规级芯片测试验证公共服务平台、5.面向光储充一体化应用的功率半导体公共服务平台、6.光电芯片微纳加工及性能测试公共服务平台。
生物医药领域:1.抗体药物重大中试平台、2.小分子化学药重大中试平台、3.生物制造重大中试平台
高端医疗器械领域:1.医疗诊断仪器及试剂重大中试平台、2.植介入及治疗设备重大中试平台
资助标准:
半导体与集成电路领域一次性给予平台总投资20%的资助,最高不超过3000万元
生物医药、高端医疗器械领域按经评审核定的项目总投资的40%给予资助,最高不超过3000万元。
5.产业化中试补助扶持计划

扶持方向:
1.固态电池中试
面向新能源汽车领域,聚焦固态电池正极、负极、电解质体系应用等
2.超宽温域储能电池中试
面向新能源汽车、石油、电力、通讯等储能场景,建成超宽温域储能电池中试线等
资助标准:
按经专项审计核定项目总投资的20%给予事后资助,最高不超过1000万元。
6.临床试验扶持计划
扶持方向:
支持药物、医疗器械临床试验(GCP)机构。
资助标准:
1.药物临床试验
对于药物临床试验质量管理规范(GCP)机构,为生物医药企业提供临床试验服务项目临床研究报告应在2023年4月1日到2024年3月31日期间取得,且对应的临床试验合同书不得早于取得临床研究报告前3年内,达到5、15、30项以上的,给予牵头单位最高不超过100、200、300万元资助等。
2.医疗器械临床试验
对于医疗器械临床试验质量管理规范(GCP)机构,为医疗器械企业提供临床试验服务项目临床研究报告应在2023年4月1日到2024年3月31日期间取得,且对应的临床试验合同书不得早于取得临床研究报告前2年内,达到10、20、40项以上的,给予牵头单位最高不超过100、200、300万元资助等。
7.新技术新产品示范应用推广扶持计划
扶持方向:
1.新能源领域
基于国产碳化硅功率器件的先进储能应用。
钠离子电池示范应用。
2.安全节能环保领域
工业废水处理及回用技术应用。
液冷技术创新应用。
资助标准:
按经评审核定的项目总投资40%给予资助,最高不超过1000万元。
8.产业化事后补助扶持计划
扶持方向:
1.生物医药
支持化学药、生物制品、中药、制药装备和给药装置领域。其中化学药、生物制品和中药需已开展3期临床试验或获批上市。
2.高端医疗器械
重点支持植介入器械、高端医学影像、分子诊断试剂与设备等领域。
(1)植介入器械。支持心脑及外周血管植介入器械、循环辅助器械等。
(2)高端医学影像设备。支持磁共振设备、CT成像设备、高端超声设备、新型内窥镜等。
(3)分子诊断试剂与设备。支持病原体分子诊断试剂盒、全自动核酸检测一体机等。
3.大健康
支持激光、脉冲光、超声、射频等医疗美容设备(设备需获第三类医疗器械注册证)。
4.新能源
支持锂离子电池、钠离子电池、镁离子电池、液流电池等先进电化学储能技术路线的原材料、元器件(IGBT、MOSFET、DSP等芯片)、工艺装备、电芯模组、电池管理系统(BMS)、能量管理系统(EMS)、变流器(PCS)、系统集成等储能领域。
资助标准:
待项目通过验收后,按经专项审计核定项目总投资的20%给予事后资助,最高不超过1500万元。
9.注册许可认证扶持计划
扶持方向:
事后一次性资助。对通过专家评审、现场核查的项目,市发展改革委予以批复立项。针对通过国内外注册许可认证要求、取得相关证明材料(包括临床批件、临床试验报告、国内外注册审批证明等)的创新产品,按照项目申报金额的一定比例对项目投入进行资助。所支持产品需在深圳本地进行产业转化,或委托深圳企业在本地生产。
资助标准:
事后资助。按经专项审计核定项目总投资的20%给予事后资助,最高不超过1500万元。
10.国家项目配套扶持计划
扶持方向:
对生物医药(生物制造产业领域)、智能传感器、智能终端领域承担国家发展改革部门产业项目、创新载体的给予配套支持。
资助标准:
1.生物医药(生物制造产业领域)
分阶段资助。支持国家产业创新中心建设,按照市政府相关工作文件和国家发展改革部门批复,对国家补助资金予以1:1市级资金配套支持。
2.智能传感器
分阶段资助。支持企业积极承担国家项目,按国家资助资金1:1配套支持
3.智能终端
分阶段资助。支持企业积极承担国家项目,按国家资助资金1:1配套支持。



